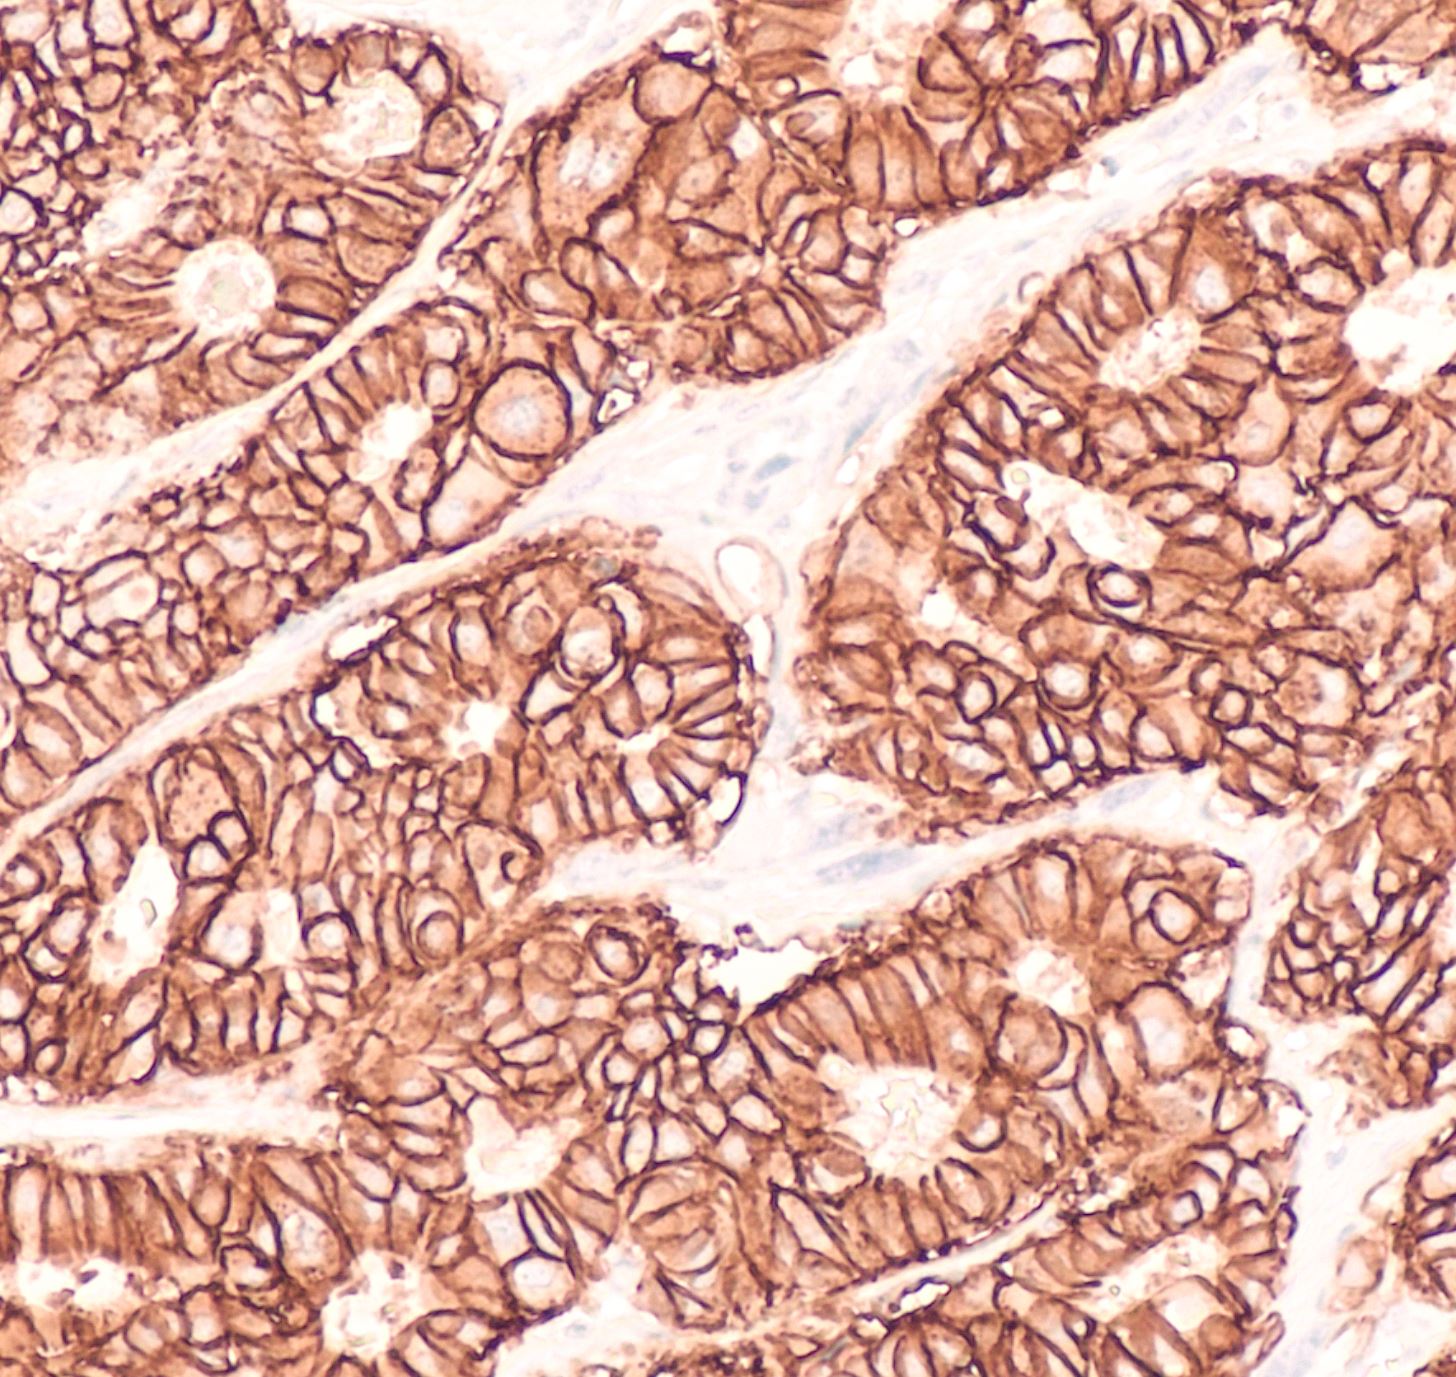
Antigen Retrieval: The Importance of Pretreatments

Formalin fixation is essential for preserving the morphology of tissue, but formalin fixation is also damaging to target antigens used in IHC, which makes various pre-treatments necessary. In formalin fixation, crosslinks are formed. Crosslinking proteins to the antigen blocks the antigenic site. Antigen retrieval or pretreatment methods are necessary to “unmask” the antigen, allowing the antibody to bind. The two most common antigen retrieval methods are heat-induced epitope retrieval (HIER) and enzymatic retrieval.
Formalin fixation is essential for preserving the morphology of tissue, but formalin fixation is also damaging to target antigens used in IHC, which makes various pre-treatments necessary. In formalin fixation, crosslinks are formed. Crosslinking proteins to the antigen blocks the antigenic site. Antigen retrieval or pretreatment methods are necessary to “unmask” the antigen, allowing the antibody to bind. The two most common antigen retrieval methods are heat-induced epitope retrieval (HIER) and enzymatic retrieval.
Heat Induced Epitope Retrieval, commonly known as HIER, works by using heat to break the fixation induced crosslinks within target proteins. There are a number of heat sources used for HIER, including microwaves, pressure cookers, water baths and steamers. All of these heat sources have their advantages and disadvantages, but they all have the goal of introducing heat. The higher the temperature, the quicker and more effectively you can restore epitope reactivity, but you run the risk of disturbing the morphology of the tissue if it gets too hot. You don’t want boiling. This is particularly a risk with pressure cookers. You also have some tissue that will fall off the slide if heated too hot. A water bath method is usually more suited to those tissues. If you use a heat source with a lower temperature, such as a water bath, it is going to require more time to compensate for the lower temperature, which is the downside of water baths and vegetable steamers, which will preserve tissue morphology better, but take longer. Microwaves are the least commonly used today of these heat sources due to inconsistencies. Have you ever microwaved some leftovers and part of your food is scalding, and part is still cold? Exactly. Uneven heating doesn’t produce the best, most consistent staining quality.
In addition to heat, HIER requires a buffer or retrieval solution, commonly either citrate, tris or EDTA-based, which the slides are immersed in, in the staining dish. The salts in the buffers help stabilize the protein. The antibody vendor will usually tell you which reagent should be used. You can usually sub in a different brand of solution, but you want to use the same type of reagent (citrate, tris, or EDTDA) and pH as what the antibody vendor says to use to get the best results.
The other method of antigen retrieval is enzyme digestion, also commonly seen as protease-induced epitope retrieval. This method uses an enzyme, typically either Pepsin, Protease, or Trypsin to remove material adjacent to the target protein which allows better access to the target epitope. There are two methods for PIER, either adding the enzyme directly to the slide, or immersing the slides in a staining dish containing the enzyme. If you are processing a lot of slides, it might be faster to put them on a rack and immerse them, as opposed to adding enzyme to each slide. PIER is less common than HIER because it has the potential, while it is degrading peptides, to mess with the antigen itself.
In addition to the two primary methods of antigen retrieval, there are also several secondary pre-treatments that may be recommended. One of these is the addition of an endogenous enzyme quenching agent. For example, you may apply a weak hydrogen peroxide solution to the sample to burn up or exhaust the naturally occurring peroxidase enzyme so that it doesn’t react. This helps eliminate background staining. Another of these pretreatments is endogenous protein blocking. These get in the way of a reaction that would otherwise take place to reduce non-specific binding between the antibody and things that aren’t the antigen, such as immunoglobulins.
You can learn more about antigen retrieval in NSH’s QIHC Prep Course, available on our Online Learning Center, elearn.nsh.org.
References:
https://www.leicabiosystems.com/knowledge-pathway/technical-brief-of-heat-induced-epitope-retrieval/
https://www.abcam.com/protocols/ihc-antigen-retrieval-protocol
http://www.ihcworld.com/_technical_tips/antigen_retrieval_tips.htm
https://www.novusbio.com/support/support-by-application/antigen-retrieval/protocol.html
https://www.rndsystems.com/resources/protocols/antigen-retrieval-methods#:~:text=can%20be%20pronounced.-,Protease%2Dinduced%20Epitope%20Retrieval%20(PIER),may%20be%20masking%20the%20epitope.
https://bitesizebio.com/22367/pier-hier-and-mannich-antigen-retrieval-in-immunohistochemistry/
#2021#Blog#IHCandMolecular